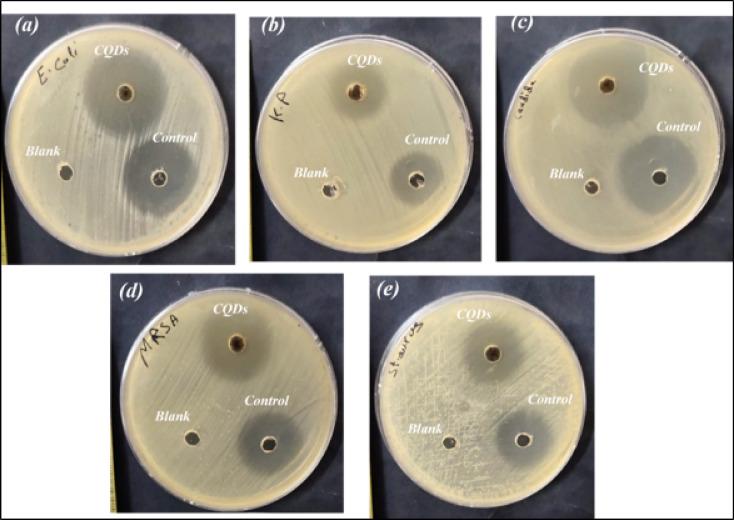
https://cdn.ncbi.nlm.nih.gov/pmc/blobs/3619/12064798/04f26e8a700a/41598_2025_99841_Fig11_HTML.jpg

源自洋蓟叶的绿色合成发光碳量子点的体外抗菌和抗癌潜力。
In vitro antimicrobial and anticancer potentials of green synthesized luminescent carbon quantum dots derived from artichoke leaves.
作者信息
Diab Eman Abo, Ghali M, Mosaad M M
机构信息
Physics Department, Faculty of Science, Kafrelsheikh University, Kafr El-Sheikh, 33516, Egypt.
Institute of Basic and Applied Sciences, Egypt-Japan University of Science and Technology, New Borg Al-Arab, Alexandria, 21934, Egypt.
出版信息
Sci Rep. 2025 May 9;15(1):16199. doi: 10.1038/s41598-025-99841-9.
Naturally derived carbon quantum dots (CQDs) are novel carbon-based nanomaterials with excellent traits. It is highly demanded to develop CQDs from biowaste that have excellent photostability, a simple synthesis approach, and an appealing output so that they can be used widely in various fields. Herein, highly fluorescent CQDs were synthesized hydrothermally using artichoke leaves. The CQDs were synthesized and analyzed for their structure, optical properties, antimicrobial, and anticancer activities. The CQDs exhibited antimicrobial action against a single fungus strain in addition to Gram-positive and Gram-negative cells; also, the cytotoxicity against the MCF-7 cell line was evaluated as 96.5 µg/mL. The findings indicated that the spherical dots have a semi-spherical shape with the smallest size of 2.88 nm, and a zeta potential value of 37.31 V, thus confirming that the synthetic CQDs are in an outstanding colloidal state. When photoexcited at 320 nm, the dots were found to show blue fluorescence at 398 nm with a fluorescence quantum yield of 3.32%, long fluorescence decay time, high photostability, and good sensing for hydrogen peroxide. Additionally, the effect of ionic strength was evaluated.
天然衍生的碳量子点(CQDs)是具有优异特性的新型碳基纳米材料。迫切需要从生物废料中开发出具有优异光稳定性、简单合成方法和良好产出的碳量子点,以便它们能在各个领域广泛应用。在此,使用洋蓟叶通过水热法合成了高荧光碳量子点。对合成的碳量子点进行了结构、光学性质、抗菌和抗癌活性分析。碳量子点除了对革兰氏阳性和革兰氏阴性细胞有抗菌作用外,还对单一真菌菌株表现出抗菌活性;此外,对MCF-7细胞系的细胞毒性评估为96.5μg/mL。研究结果表明,球形量子点呈半球形,最小尺寸为2.88nm,zeta电位值为37.31V,从而证实合成的碳量子点处于优异的胶体状态。当在320nm处光激发时,发现这些量子点在398nm处呈现蓝色荧光,荧光量子产率为3.32%,荧光衰减时间长,光稳定性高,对过氧化氢具有良好的传感性能。此外,还评估了离子强度的影响。